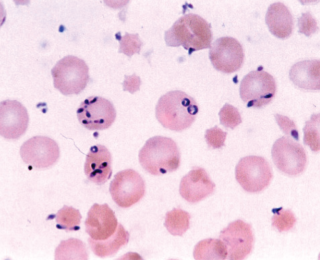

Focus > Herd Health - April 2020
Redwater infection – clinical signs and treatment
Babesiosis, or redwater, is a cattle disease caused, in Ireland, by the protozoan parasite Babesia divergens transmitted by the tick Ixodes ricinus. The disease is associated with animals grazing on rough pastures and can result in production losses in addition to possible mortality, writes Natascha Meunier, programme manager, Beef HealthCheck, Animal Health Ireland
Click on image to view
Clinical signs
The classic clinical sign, giving the disease its name, is haemoglobinuria caused by rupturing of the red blood cells, which results in an increase in haemoglobin in the blood and urine. The dark red-brown urine is often the first sign seen by the farmer, but once this is observed, the disease is already advanced with extensive destruction of the erythrocytes. Timely identification and treatment improve the prognosis. Early signs include reduced appetite, fever and ‘pipe-stem’ diarrhoea, although some infected animals may only have mild parasitaemia with few clinical signs, which may go unnoticed and recover uneventfully (Zintl et al, 2003). As the disease progresses, the following signs have been reported: anaemia; tachycardia; jaundice; weakness; constipation; low body temperature; recumbency; and ultimately death. Late-term pregnant animals may abort even with successful treatment. Cattle with no previous exposure to the parasites or that are in poor condition may be more severely affected. Severely anaemic animals have been known to become aggressive or show neurological signs due to brain hypoxia.
Available treatments
In Ireland, imidocarb dipropionate is the only drug registered for use and is very effective but can be associated with side-effects such as muscle tremors and salivation. The withdrawal periods of this drug are extremely long in meat-producing animals (213 days) and 21 days in milk. Supportive treatments can be administered including anti-inflammatories, blood transfusions, and iron and vitamin supplements to support red blood cell production.
Epidemiology
In Ireland, the distribution of the tick is most prevalent in the west and northwest, as well as along the Shannon river system (Zintl et al, 2017). However, tick concentrations and infection may be localised to areas where the habitat is favourable for the tick. Ixodes ricinus is prone to desiccation and requires conditions with a high relative humidity which can be found at the base of dense vegetation. Unimproved or under-grazed pastures, rough scrub and damp low-lying fields are favoured by the ticks. The first cases of babesiosis usually occur two weeks after the ticks become active, which occurs above temperatures of 7-10°C. This results in high-risk periods for tick activity during spring (April-June) and autumn (August-October) throughout Europe. Irish summers often remain mild with cases possible throughout the summer and even some cases reported in winter (Zintl et al, 2014).
All feeding stages of the tick (larva to adult) can transmit the Babesia parasite to cattle. The tick has a three-year life cycle and the parasite can be passed from one stage of the tick to the next as well as via the transovarial route. This implies that infection can persist in an area for a number of years, even if ticks only feed on uninfected animals. Calves express a natural immunity to babesiosis compared to adult cattle, allowing time for the animals to develop an active immunity if they are exposed to the parasites before six months of age. This phenomenon, known as inverse age resistance, explains why heavily infested areas of the country usually do not see clinical cases. This endemic stability exists where tick densities are high and subsequently incidence of disease is low. In areas with patchy coverage of infected ticks, there may be some animals that do not become exposed as calves and are fully susceptible to disease.
Prevention and control
Disease prevention involves tick control through acaricides or pasture management and in endemic areas, through the development of immunity. Topical treatments with products containing flumethrin or amitraz help control ticks and should be used at high-risk periods. Pasture management to prevent under-grazing and overgrowth, clearing scrub and other grassland improvement practices reduce favourable habitat for ticks. Margins near hedges, for example, may still be a suitable environment for ticks.
If the farm is in a known endemic area, any animals that are bought in should also preferably be from an endemic area. Alternatively, buying of young stock and ensuring they are exposed to ticks can allow the development of natural immunity. Overuse of acaricides in young animals in endemic areas can prevent this beneficial exposure. Keep naïve animals older than six months old away from high-risk grazing areas during expected periods of peak tick activity and closely monitor animals brought from outside the area for at least three weeks after introduction.
Imidocarb dipropionate can be used prophylactically at twice the therapeutic dose to provide protection from clinical disease, during which time cattle can be exposed to ticks to allow the development of natural immunity (Vial et al, 2006). If the animals do not become infected during the four weeks of persistence of drug, they will again become susceptible to disease. Adult animals maintain immunity by constant challenge with infected ticks and with decreasing exposure, may become susceptible once more.
Although environmental conditions have favoured the spread of the Ixodes habitat in Europe, there is evidence that clinical cases of babesiosis in cattle are decreasing in Ireland (Zintl et al, 2014). This is presumed to be due to improvements in pasture management that remove tick habitats. Also, although there is no scientific evidence to support it, the widespread use of macrocyclic lactones is thought by farmers and practitioners to reduce the level of ticks on pasture (Zintl et al, 2017). This decrease in incidence of disease and in the extent of endemic areas can mean that veterinary practitioners and farmers become less familiar with the disease and less able to recognise clinical signs early. Previously endemic areas may see occasional outbreaks as the immunity in cattle herds wanes over time.
-
Vial HJ, Gorenflot A. 2006. Chemotherapy against babesiosis. Veterinary Parasitology. Volume 138, Issues 1-2, Pages 147-160. https://doi.org/10.1016/j.vetpar.2006.01.048
-
Zintl A, Mulcahy G, Skerrett HE, Taylor SM et al. 2003. Babesia divergens, a Bovine Blood Parasite of Veterinary and Zoonotic Importance. Clin. Microbiol. Rev. 16, 622-636. doi:10.1128/CMR.16.4.622-636.2003
-
Zintl A, McGrath G, O’Grady L, Fanning J, et al. 2014. Changing incidence of bovine babesiosis in Ireland. Ir. Vet. J. 67, 19. doi:10.1186/2046-0481-67-19
-
Zintl A, Moutailler S, Stuart P, Paredis L, et al. 2017. Ticks and Tick-borne diseases in Ireland. Ir. Vet. J. doi:10.1186/s13620-017-0084-y